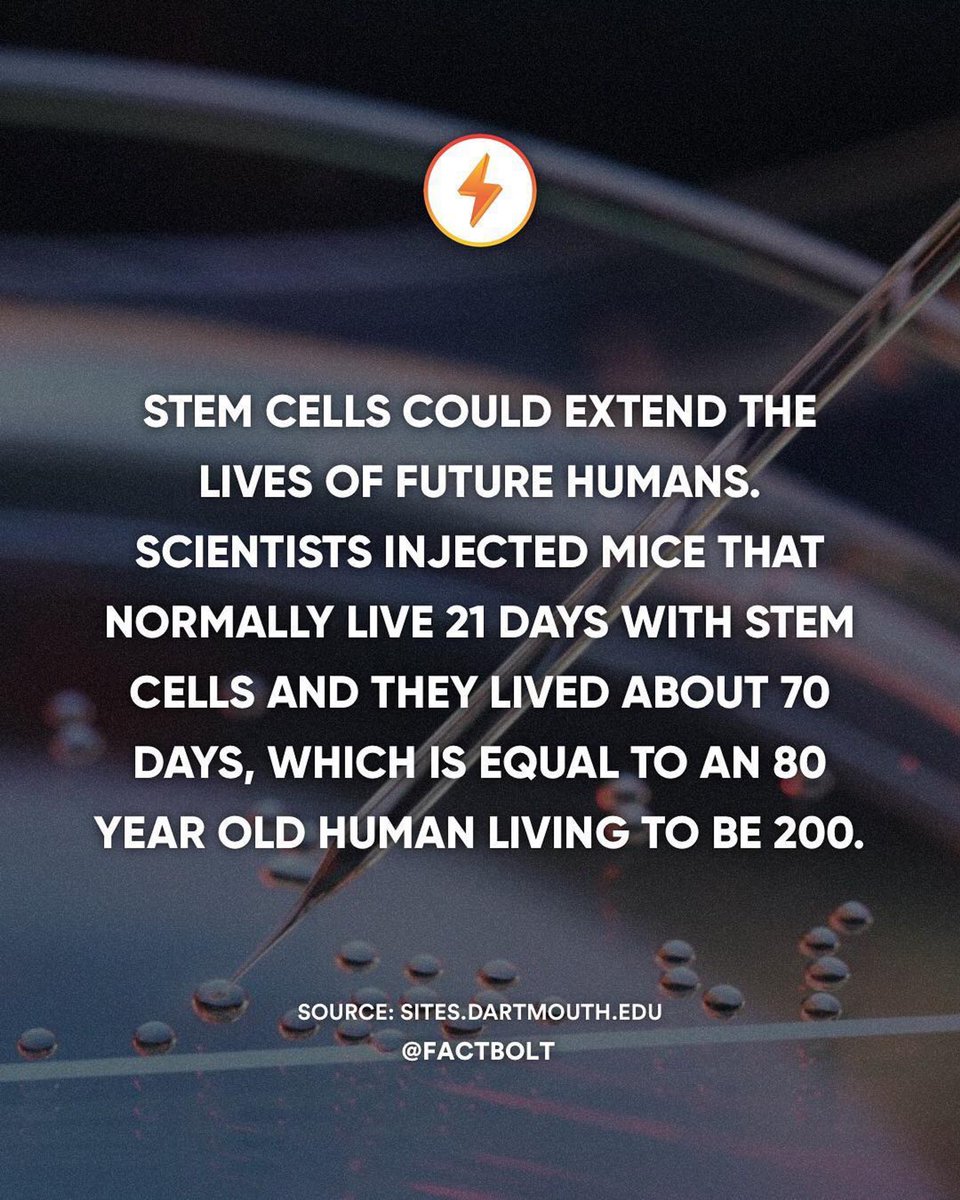
via <a href="/factbolt/">factbolt</a> #stem #stemcellresearch #stemcells #Caverstem
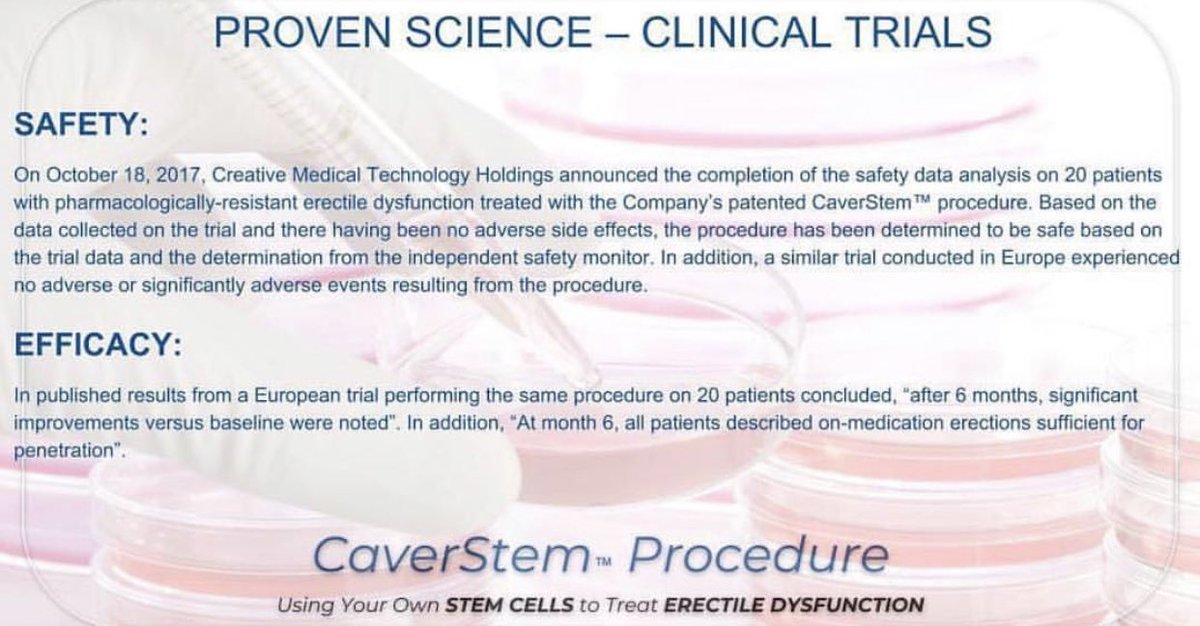
Proven Science ☝🏼#CaverStem #ErectileDysfunction #SoCal #LosAngeles #California #Urology

Institute for Advanced Urology
@gershmanmdla
Revolutionary painless single treatment that is cost effective & requires no medicine. #CaverStem dramatically enhances male performance (up to 90%) in 45 mins.
ID: 996889654765879297
http://goo.gl/zgxDfV 16-05-2018 23:06:29
229 Tweet
887 Followers
604 Following


















One week follow up from Greg sevdagian after his CaverStem procedure. #CAVERSTEM™ Enhances performance up to 90% • 310.623.1911 #urology #stemcells #health #biotechnology #ErectileDysfunction #MEDTECH $celz @CelzFans antoniniurology Dr Amit Patel @mbmd17 Elias Said, MD, FACEP